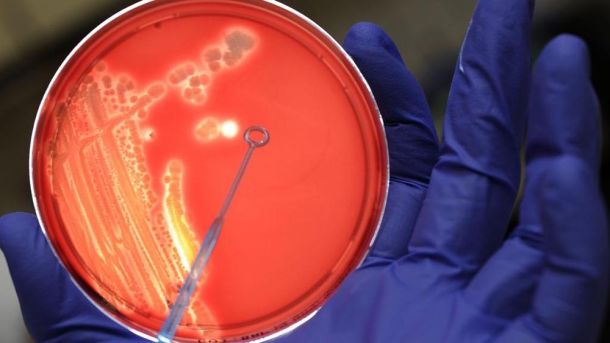

Sanità: vaccino universale contro il cancro messo a punto e testato da studiosi tedeschi

MAINZ – Messo a punto e testato per ora su tre pazienti un vaccino terapeutico “universale” efficace contro tutti i tipi di cancro. E’ quello a cui sta lavorando un gruppo di ricercatori dell’Università Johannes Gutenberg a Mainz (Germania), il quale ha ideato una strategia davvero molto promettente, descritta in un articolo pubblicato sulla rivista Nature. I ricercatori tedeschi hanno creato un vaccino in grado di indurre una forte risposta del sistema immunitario al cancro, utilizzando “proiettili” rivestiti da grassi (liposomi) e “infarciti” da nanoparticelle di Rna.
Secondo quanto riferito sulla rivista, la sua unicità sta nel fatto che il vaccino funziona in maniera semplicissima e induce una forte reazione immunitaria: iniettato endovena, infatti, raggiunge i distretti immunitari del corpo (milza, linfonodi, midollo osseo) dove attiva una forte risposta immunitaria contro il tumore, sostenuta nel tempo.
«Per ora – spiega all’Ansa Ugur Sahin, ricercatore che ha condotto il lavoro – abbiamo ancora una evidenza clinica limitata, poiché abbiamo testato il vaccino su soli tre pazienti. Comunque questi sono rimasti stabili, il che significa che i loro tumori hanno smesso di crescere dopo la vaccinazione e per tutto il periodo di osservazione». «Nel 2017 – anticipa Sahin – testeremo il vaccino su altri pazienti con diversi tipi di tumore».
«La grande novità di questo lavoro – spiega Enrico Proietti, Direttore del reparto di applicazioni cliniche delle terapie biologiche dell’Istituto Superiore di Sanità – sta nel fatto che questi ‘liposomì (gli involucri di grasso che racchiudono il vaccino) sono molto efficaci nell’indurre una forte risposta immunitaria, sia perché attivano l’interferone, sia perché raggiungono quasi tutti la milza, centro nevralgicò delle reazioni immuni.
Il vaccino è stato testato con successo sui topi e su tre pazienti affetti da melanoma in stadio avanzato. Già a basse dosi, si è mostrato capace di attivare una risposta immunitaria efficace contro il tumore. Tuttavia, questo approccio potrebbe essere efficace anche per molti altri tipi di tumori. “Dipende dal tipo di Rna che viene caricato nelle vescicole di grasso”, precisa Michele Maio, direttore UOC dell’Azienda Ospedaliera Universitaria Senese e ricercatore dell’Associazione italiana per la ricerca sul cancro (Airc).

